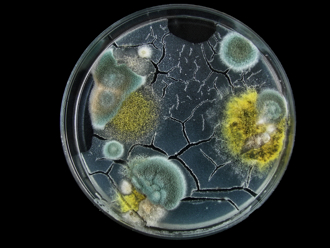
下雨潮湿身体会发霉 重症医喊5类人小心：严重恐害命

搜寻结果
以下是含有念珠菌的搜寻结果,共37笔
-
感冒乱吃抗生素更惨!36岁男喉咙「长满雪花」超惊悚 医生示警了
秋冬交替时节为呼吸道疾病高发期,不少人感冒喉咙痛时会自行服用抗生素「消炎」,却因此延误治疗时机。大陆浙江省寧波市36岁张先生(化名)因喉咙痛擅自吃抗生素,结果病情恶化。北仑区第二人民医院耳鼻喉科主任邬忠伟检查发现,他的咽喉后壁布满白色斑点,确诊为真菌性咽喉炎,元凶是白色念珠菌。
-
不是洗了就没事!内裤穿久细菌多8倍 3到6个月就该换
常洗内裤就能穿更久?研究发现,清洗后的内裤上,平均仍残留约0.1公克粪便颗粒,相当于几百万个大肠杆菌,使用寿命为3至6个月,若超过一年,细菌密度可达新衣服的8至10倍,这些微生物在潮湿温暖的环境下,可能导致私密处反覆搔痒、感染、甚至诱发泌尿道炎症等疾病。
-
下雨天脚没吹乾恐变细菌温床!感染、臭味全都来
台湾各地近日降雨不断,许多人一出门没走几步就被淋成落汤鸡,鞋子、袜子也被浸湿,迫使双脚闷在潮湿鞋内一整天都乾不了,这样的「闷湿」环境不只让人难受,还可能让脚部成为细菌与霉菌的天堂!
-
长期待潮湿地下室工作 51岁妇突发烧2周确诊念珠菌肺炎
工作环境有可能影响劳工身体健康!近日大陆一名51岁赵姓妇人(化名)任职于某间食品厂,她长时间在阴暗潮湿且不通风的地下室洗菜,突然发高烧连续2周没好转,加上胸痛及咳出黄色黏痰;赵女就医检查,确诊罕见的念珠菌肺炎,所幸经治疗后已康復。
-
标榜无糖、低脂更伤!改用人工添加物害肠又害脑
饮食与健康息息相关。家医科医师李思贤表示,过去大家以为少油少糖就是健康,其实很多标榜无糖、低脂的超加工食品,对肠道微生物群伤害更大,里面的人工甜味剂等添加物,会形成多重菌相破坏力,透过肠脑轴伤害大脑功能,并导致身体发炎,提高糖尿病、肥胖,甚至是神经退化性疾病风险。
-
无糖低脂恐藏毁肠陷阱 医最怕它:极少量就杀死一半好菌
少油少糖有益健康,但加工食品藏着许多陷阱,却常被忽略。医师李思贤指出,许多标榜无糖、低脂的加工食品,其实添加物对肠道微生物群造成的伤害远比想的还深,其中,最令人担心的就是人工甜味剂,像是三氯蔗糖和阿斯巴甜,只要极少量就会杀死一半以上的好菌,摄取两周,还会透过干扰肠道菌相,让血糖调节变得更差。
-
内裤没破继续穿超NG 医揭严重后果:感染一路烧进体内
内裤没破继续穿?当心细菌、霉菌在上面开派对,医师张瑜芹指出,内裤一定要定期汰换,因为外阴的黏膜组织结构就像嘴巴、鼻腔,极易感染,内裤没洗乾净、洗衣机又没消毒的话,会让旧内裤成为私密处反覆感染的温床,严重时感染会扩散至子宫、输卵管,松掉、有黄渍、有味道就该淘汰。
-
下雨潮湿身体会发霉 重症医喊5类人小心:严重恐害命
大雨一直下,让环境变得潮湿,不只食物容易发霉,连身体也会成为霉菌的天堂。医师黄轩指出,在潮湿、闷热或免疫力低下的情况下,霉菌会悄悄入侵皮肤皱折处、口腔黏膜、肺部、指甲。糖尿病患者、免疫抑制治疗者、长期使用抗生素或类固醇者、老年人、潮湿热带地区居民都是高风险族群,感染后若没有及时治疗,可能会深入血液,甚至威胁生命。
-
雨多高温闷热易感 蔓越莓益生菌呵护私密
进入首波梅雨季,天气不稳定,湿度高,日夜温差大,肌肤黏腻感加重,有些女性也发现私密处分泌物突然变多,伴随搔痒、异味,尤其追随妈祖遶境时,雨水、汗水交织,对私密处极为不利。面对可能的感染,医界呼吁女性建立良好卫生习惯、穿宽松衣物、勤喝水、不憋尿,预防感染。在此同时,有越来越多女性选用太阳星全效蔓越莓益生菌等健康食品,保养、调节生理机能。
-
打过疫苗仍感染麻疹?专家示警:小心「免疫失忆」
台湾麻疹疫情、疟疾都纷纷创下近年感染新纪录,疾管署最新公布,国内上周新增一例本土麻疹个案,曾接种两剂麻疹疫苗仍感染。台大公卫学者陈秀熙指出,全球传染病风险持续上升,尤其麻疹会让病患发生「免疫失忆」,让所有免疫细胞失去原先抵抗其他病毒感染的记忆性,要修正终身免疫的观念,且WHO也首度发布真菌感染检测与治疗报告,警告全球侵入性真菌感染的药物与诊断工具严重不足,对癌症治疗等免疫低下族群威胁日增。
-
台湾AV女优自爆「下体有怪异臭味」 因2隐疾发文求解
台湾AV女优胎尼(Tiny)拥有天使脸孔及魔鬼身材,去年2月底以艺名「田井虹」宣布进军日本AV界。不时会在社群分享日常的她,近日自曝下体一直传出不寻常的味道,形容「像保险套的橡胶味」,让她感到相当困惑,贴文曝光后,引发不少热心网友留言。
-
GG好痒不一定是性病 医揪凶手:4情况易中镖
男性若发现私密处发红、搔痒、甚至有异味或白色分泌物时,不免会担心是否罹患性病。对此,泌尿科医师施冠伟表示,可先不用太紧张,有可能是因感染念珠菌而引起的「包皮龟头炎」,其成因包括不良卫生习惯、性行为未戴套、免疫功能低下,以及慢性病影响。他并提醒,做好日常清洁和保持好的免疫力,是预防包皮龟头炎的不二法门,才能确保GG长久「战力」。
-
女下体肿3倍发臭流汤「1习惯害惨」医嘆:再拖恐坏死
一名女子内诊时,被发现外阴部竟肿成原本的3倍大。进一步探究才得知,原来她平常爱穿紧身裤,不通风的材质导致私密处容易发痒,又经常去抠抓,使私密处逐渐肿大,拖了3周直到发臭、流汤才就诊。医师直言,若就医时间再拖延,恐恶化为坏死性筋膜炎,引发全身性感染,后果不堪设想。
-
性行为后多喝水 防阴尿道合併发炎
未落实安全性行为,除了增加性病传染率,也可能增加年轻女性阴道、尿道感染机会。医师指出,临床上许多女性常同时感染阴道炎及尿道炎,导致分泌物增多,并出现频尿、解尿疼痛状况,建议民眾平时多提升免疫力、保持私密处乾净,从事性行为后也应多喝水、排尿及清洁,若是透过性行为感染,一定要和伴侣一同接受治疗。
-
4种人别穿发热衣 医示警:不保暖还可能引发灾难
受大陆冷气团影响,局部地区出现10度以下低温,民眾纷纷穿上厚外套、围巾、发热衣等御寒衣物,北市立联合医院和平妇幼院区皮肤科主任李孟穗提醒,4种人穿发热衣恐引发「灾难」,分别是新陈代谢快、痘痘肌、异位性皮肤炎患者、冬季乾痒肤质等,由于台湾不像欧美国家般严寒,进入室内仍有20度,穿发热衣反而会不舒服,建议最好採取洋葱式多层次穿搭。
-
经期 孕期 更年期 蔓越莓益生菌助私密保养
女性一生健康与卵巢分泌的雌激素、黄体素息息相关,尤其是私密处出现的各种问题,所以不论在月经来临前的儿童期,或大姨妈出现后的青春岁月、怀孕期,甚至停经之后的更年期,私密处都需要好好保养,太阳星全效蔓越莓益生菌就是最佳帮手。
-
全效蔓越莓益生菌 女性专属健康「闺蜜」
重视自我健康的消费者日益增多,益生菌保健食品市场快速扩张的同时,也精准导向分眾市场,尤以女性专属私密处保养的蔓越莓益生菌最热门。新上市的太阳星全效蔓越莓益生菌更以益生菌、益生元、后生元黄金三角配方,结合加拿大的高浓缩蔓越莓、欧美时尚女性保养圣品D-甘露糖、6支专利益生菌,打造每日轻保养的女性专属健康「闺蜜」。
-
脚指甲变黑一验竟是「皮肤癌王」医:冒白点也要小心
一名70多岁妇人足部大拇趾指甲呈现黑色,家人见状觉得不太对劲,便赶紧带去就医。原本她还不以为意,未料检查结果显示为「黑色素细胞癌」,其素有皮肤癌王恶名,死亡率非常高。然而,除了指甲变黑要注意外,医师表示,若突然冒出很多白点、白线或整片泛白,也要留意心臟病、肾臟衰竭等疾病徵兆。
-
女性的15种超级食物!酪梨、核桃全上榜
人人都需要营养,但某些食物对女性健康特别有益,像是主要由豆科植物分泌的天然贺尔蒙「异黄酮」,或是被视为孕妇营养补充品的叶酸,适当摄取即能维持身体健康,现在就来看看女性必吃的超级食物有哪些!
-
私密处长痘痘6原因 医:2徵兆恐癌症警讯
不只脸上会长痘痘,私密处也可能冒出异常颗粒物,到底原因为何?对此,医师指出,女性私密处长痘痘可能是6种疾病所致,分别是毛囊炎、巴氏腺囊肿、疱疹、菜花、念珠菌感染及湿疹。值得注意的是,若痘痘在短期间变大,或2、3个月都没有消失,务必尽快就医诊断是否为癌症。